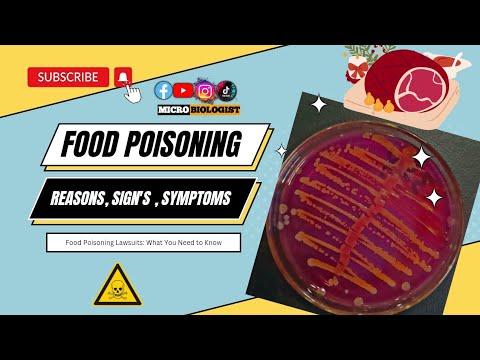
Food Poisoning: Causes, Symptoms, and Prevention || Food Poisoning Lawsuits: What You Need to Know

No products in the cart.
Comprehensive Guide to Food Poisoning Lawsuits: What You Need to Know
Contents
hide
Food poisoning can be a devastating experience, leaving you with severe stomach cramps, diarrhea, and even life-long health consequences. If you’ve recently fallen victim to food poisoning, you’re likely wondering if you can hold the restaurant accountable. The answer is yes, but navigating the complex process of filing a lawsuit can be daunting. In this guide, we’ll walk you through the common symptoms of food poisoning, the time limits for filing a lawsuit, and the essential evidence needed to support your claim. We’ll also cover topics like suing restaurants for takeout or delivery, settling out of court, and dealing with liability waivers. Whether you’re a victim of food poisoning or a concerned consumer, this guide will equip you with the knowledge to take action and seek justice.
🔑 Key Takeaways
- Be aware of the common symptoms of food poisoning to identify potential cases
- Know the time limits for filing a food poisoning lawsuit in your state
- Gather essential evidence, such as receipts and medical records, to support your claim
- Understand the differences in liability between restaurants and fast-food chains
- Consider hiring an attorney to navigate the complex process of filing a lawsuit
- Be aware of the potential risks and benefits of settling a food poisoning case out of court
- Understand the implications of signing a liability waiver on your ability to sue
Recognizing the Symptoms of Food Poisoning
Food poisoning can manifest in different ways, but common symptoms include nausea, vomiting, diarrhea, stomach cramps, and fever. These symptoms can range from mild to severe and may appear within hours or days of consuming contaminated food. To determine if you’ve contracted food poisoning, pay attention to the timing of your symptoms and the food you’ve eaten. If you’ve consumed food from a restaurant or store and experience these symptoms, it’s essential to seek medical attention and document your experience.
Time Limits for Filing a Food Poisoning Lawsuit
The time limits for filing a food poisoning lawsuit vary by state, but most have a statute of limitations of one to three years. This means that if you’ve fallen ill due to food poisoning, you generally have one to three years to file a lawsuit. It’s crucial to consult with an attorney to determine the specific time limit in your state and to ensure you don’t miss the deadline. Filing a lawsuit within the time limit can significantly impact the outcome of your case and the compensation you may receive.
Gathering Evidence for a Food Poisoning Lawsuit
To support your food poisoning lawsuit, you’ll need to gather essential evidence, such as receipts, medical records, and witness statements. Keep a record of your symptoms, including when they started, how they progressed, and any treatments you received. Documenting your experience can help establish a connection between the contaminated food and your symptoms. Additionally, save any receipts or packaging from the food you consumed, as these can serve as crucial evidence in your case.
Suing Restaurants for Takeout or Delivery
Food poisoning can occur from takeout or delivery, and you may still be able to sue the restaurant. However, the process may be more challenging due to the lack of direct evidence. To increase your chances of a successful lawsuit, gather evidence of the food’s origin, such as receipts or packaging, and document your experience. Consult with an attorney to determine the feasibility of your case and the best course of action.
Settling a Food Poisoning Case Out of Court
Settling a food poisoning case out of court can be a viable option, but it’s essential to consult with an attorney before making a decision. A settlement can provide a quicker resolution to your case and may offer a more substantial compensation than a court trial. However, be aware that settling out of court may mean waiving your right to further compensation in the future. Your attorney can help you weigh the pros and cons of settling and ensure you receive a fair outcome.
Multiple People Falling Ill from the Same Restaurant
If multiple people have fallen ill from the same restaurant, it may indicate a larger issue with food safety. In such cases, the restaurant may be more likely to take responsibility for the contamination, and you may be able to file a class-action lawsuit. Consult with an attorney to determine the feasibility of a class-action lawsuit and the benefits of joining forces with other affected individuals.
Liability Waivers and Food Poisoning Lawsuits
Liability waivers can be complex and may impact your ability to sue a restaurant for food poisoning. If you’ve signed a liability waiver, it’s essential to consult with an attorney to determine the implications on your case. In some cases, liability waivers may not be enforceable, and you may still be able to file a lawsuit. Your attorney can help you navigate the nuances of liability waivers and ensure you receive a fair outcome.
Restaurant Liability and Fast-Food Chains
Fast-food chains and restaurants have different liability structures, which can affect your ability to sue. Fast-food chains may have more stringent safety protocols and quality control measures in place, which can reduce the risk of food poisoning. However, restaurants may have more flexibility in their food preparation and handling procedures, which can increase the risk of contamination. Consult with an attorney to determine the specific liability structure of the restaurant you’re suing and the implications on your case.
Funding a Food Poisoning Lawsuit
Funding a food poisoning lawsuit can be challenging, especially if you’re experiencing financial difficulties. Consider hiring an attorney who offers contingency fees or sliding scale rates to make the process more affordable. Additionally, you may be able to pursue alternative funding options, such as crowdfunding or loans, to support your case. Consult with an attorney to determine the best funding options for your situation and to ensure you receive the compensation you deserve.
Filing a Food Poisoning Lawsuit Against a Fast-Food Chain
Filing a food poisoning lawsuit against a fast-food chain can be more complex than suing a local restaurant. Fast-food chains may have more resources and a stronger defense, which can make it more challenging to win your case. However, if you’ve fallen ill due to contaminated food from a fast-food chain, you may still be able to file a lawsuit. Consult with an attorney to determine the feasibility of your case and the best course of action.
Implications of Food Poisoning
Food poisoning can have severe implications, including life-long health consequences, lost wages, and increased medical expenses. If you’ve fallen ill due to food poisoning, it’s essential to seek medical attention and document your experience. By gathering evidence and consulting with an attorney, you can hold the restaurant accountable and receive the compensation you deserve.
❓ Frequently Asked Questions
Can I file a food poisoning lawsuit if I’m still experiencing symptoms?
Yes, you can file a food poisoning lawsuit even if you’re still experiencing symptoms. However, it’s essential to seek medical attention and document your experience to establish a connection between the contaminated food and your symptoms. Consult with an attorney to determine the best course of action and to ensure you receive the compensation you deserve.
How do I know if I have a valid food poisoning case?
To determine if you have a valid food poisoning case, consult with an attorney who specializes in food poisoning lawsuits. They can help you gather evidence, assess the strength of your case, and determine the best course of action. Additionally, consider seeking medical attention to document your experience and establish a connection between the contaminated food and your symptoms.
Can I file a food poisoning lawsuit if I’m not sure what caused my illness?
Yes, you can file a food poisoning lawsuit even if you’re not sure what caused your illness. However, it’s essential to gather evidence and consult with an attorney to determine the feasibility of your case. Your attorney can help you navigate the complexities of food poisoning laws and ensure you receive the compensation you deserve.
How long does a food poisoning lawsuit typically take to resolve?
The length of a food poisoning lawsuit can vary depending on the complexity of the case and the court’s schedule. However, most food poisoning lawsuits can take anywhere from several months to several years to resolve. Consult with an attorney to determine the estimated timeline for your case and to ensure you receive the compensation you deserve.
Can I file a food poisoning lawsuit if the restaurant claims the food was safe?
Yes, you can file a food poisoning lawsuit even if the restaurant claims the food was safe. However, it’s essential to gather evidence and consult with an attorney to determine the feasibility of your case. Your attorney can help you navigate the complexities of food poisoning laws and ensure you receive the compensation you deserve.
Can I sue a restaurant if I’m a minor?
Yes, you can sue a restaurant if you’re a minor, but you’ll need to have a parent or guardian act as your representative. Additionally, you may need to file a lawsuit through a process called a “guardianship action.” Consult with an attorney to determine the best course of action and to ensure you receive the compensation you deserve.